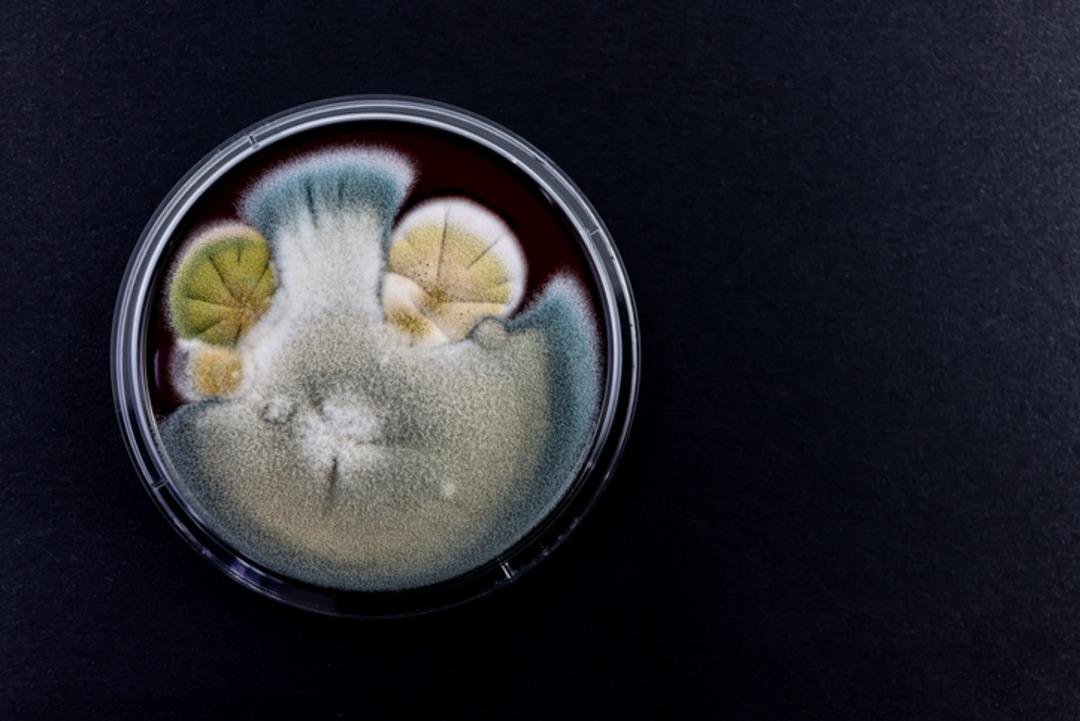
ABD alarm verdi 60 &uuml;lkede g&ouml;r&uuml;ld&uuml;: İla&ccedil;lar bile &ccedil;&ouml;z&uuml;m olmuyor! &Ouml;l&uuml;mc&uuml;l mantar hastalığı korku sa&ccedil;ıyor 4

ABD’de ilaçlara dirençli ölümcül bir mantar türünün hastanelerde hızla yayıldığı uyarısı yapıldı. Doktorlar, Candida auris (C. auris) adı verilen bu mantarın küresel çapta yayıldığını ve hem bağışıklık sistemine hem de mevcut ilaçlara karşı giderek daha dirençli hale geldiğini açıkladı.
Hackensack Meridian Keşif ve İnovasyon Merkezi (CDI) tarafından yapılan araştırmada, C. auris “acil antimikrobiyal tehdit” olarak tanımlandı. Böylece bu unvanı alan ilk mantar patojeni oldu. ABD’deki vaka sayısının hızla artması endişeleri artırdı.

ABD Hastalık Kontrol ve Önleme Merkezleri’ne (CDC) göre, ülkede şu ana kadar yaklaşık 7 bin vaka tespit edildi. Mantarın, ABD’de onlarca eyalette ve en az 60 ülkede görüldüğü bildirildi.
Araştırmanın sonuçları, Microbiology and Molecular Biology Review dergisinde yayımlandı. Uzmanlar, mevcut tedavi seçeneklerinin yetersiz kaldığını ve yeni ilaçların geliştirilmesinin şart olduğunu vurguladı.

Araştırmacılar yaptıkları açıklamada, geniş etki alanına sahip yeni antifungal ilaçların, daha gelişmiş tanı testlerinin ve bağışıklık ile aşı temelli tedavi yöntemlerinin geliştirilmesi gerektiğini belirtti. Ayrıca özellikle düşük gelirli ülkelerde mantar hastalıklarına yönelik farkındalığın artırılması çağrısı yapıldı.
Uzmanlar, bu çalışmaların hastaların yaşam şansını artıracağını ifade etti.

Araştırmacılara göre mantar, özellikle yoğun bakımda olan, solunum cihazına bağlı ya da bağışıklık sistemi zayıflamış hastalar için büyük risk oluşturuyor.
Fox News tıbbi analisti ve NYU Langone Klinik Profesörü Dr. Marc Siegel, mantarın birçok antifungal ilaca dirençli olduğunu ve hastane ortamında kolayca yayıldığını söyledi. Siegel, “Ventilatörler ve kateterler gibi tıbbi ekipmanlar üzerinden bulaşabiliyor” dedi.
Belirtilerin ateş, titreme ve vücut ağrısı gibi yaygın şikayetler olduğunu belirten Siegel, bu yüzden mantarın başka enfeksiyonlarla karıştırılabildiğini de ekledi.
Bazı hastanelerde yaşanan salgınlar nedeniyle yoğun bakım ünitelerinin geçici olarak kapatıldığı bildirildi. Buna rağmen uzmanlar, yeni geliştirilecek ilaçlarla enfeksiyonların kontrol altına alınabileceği konusunda umutlu.